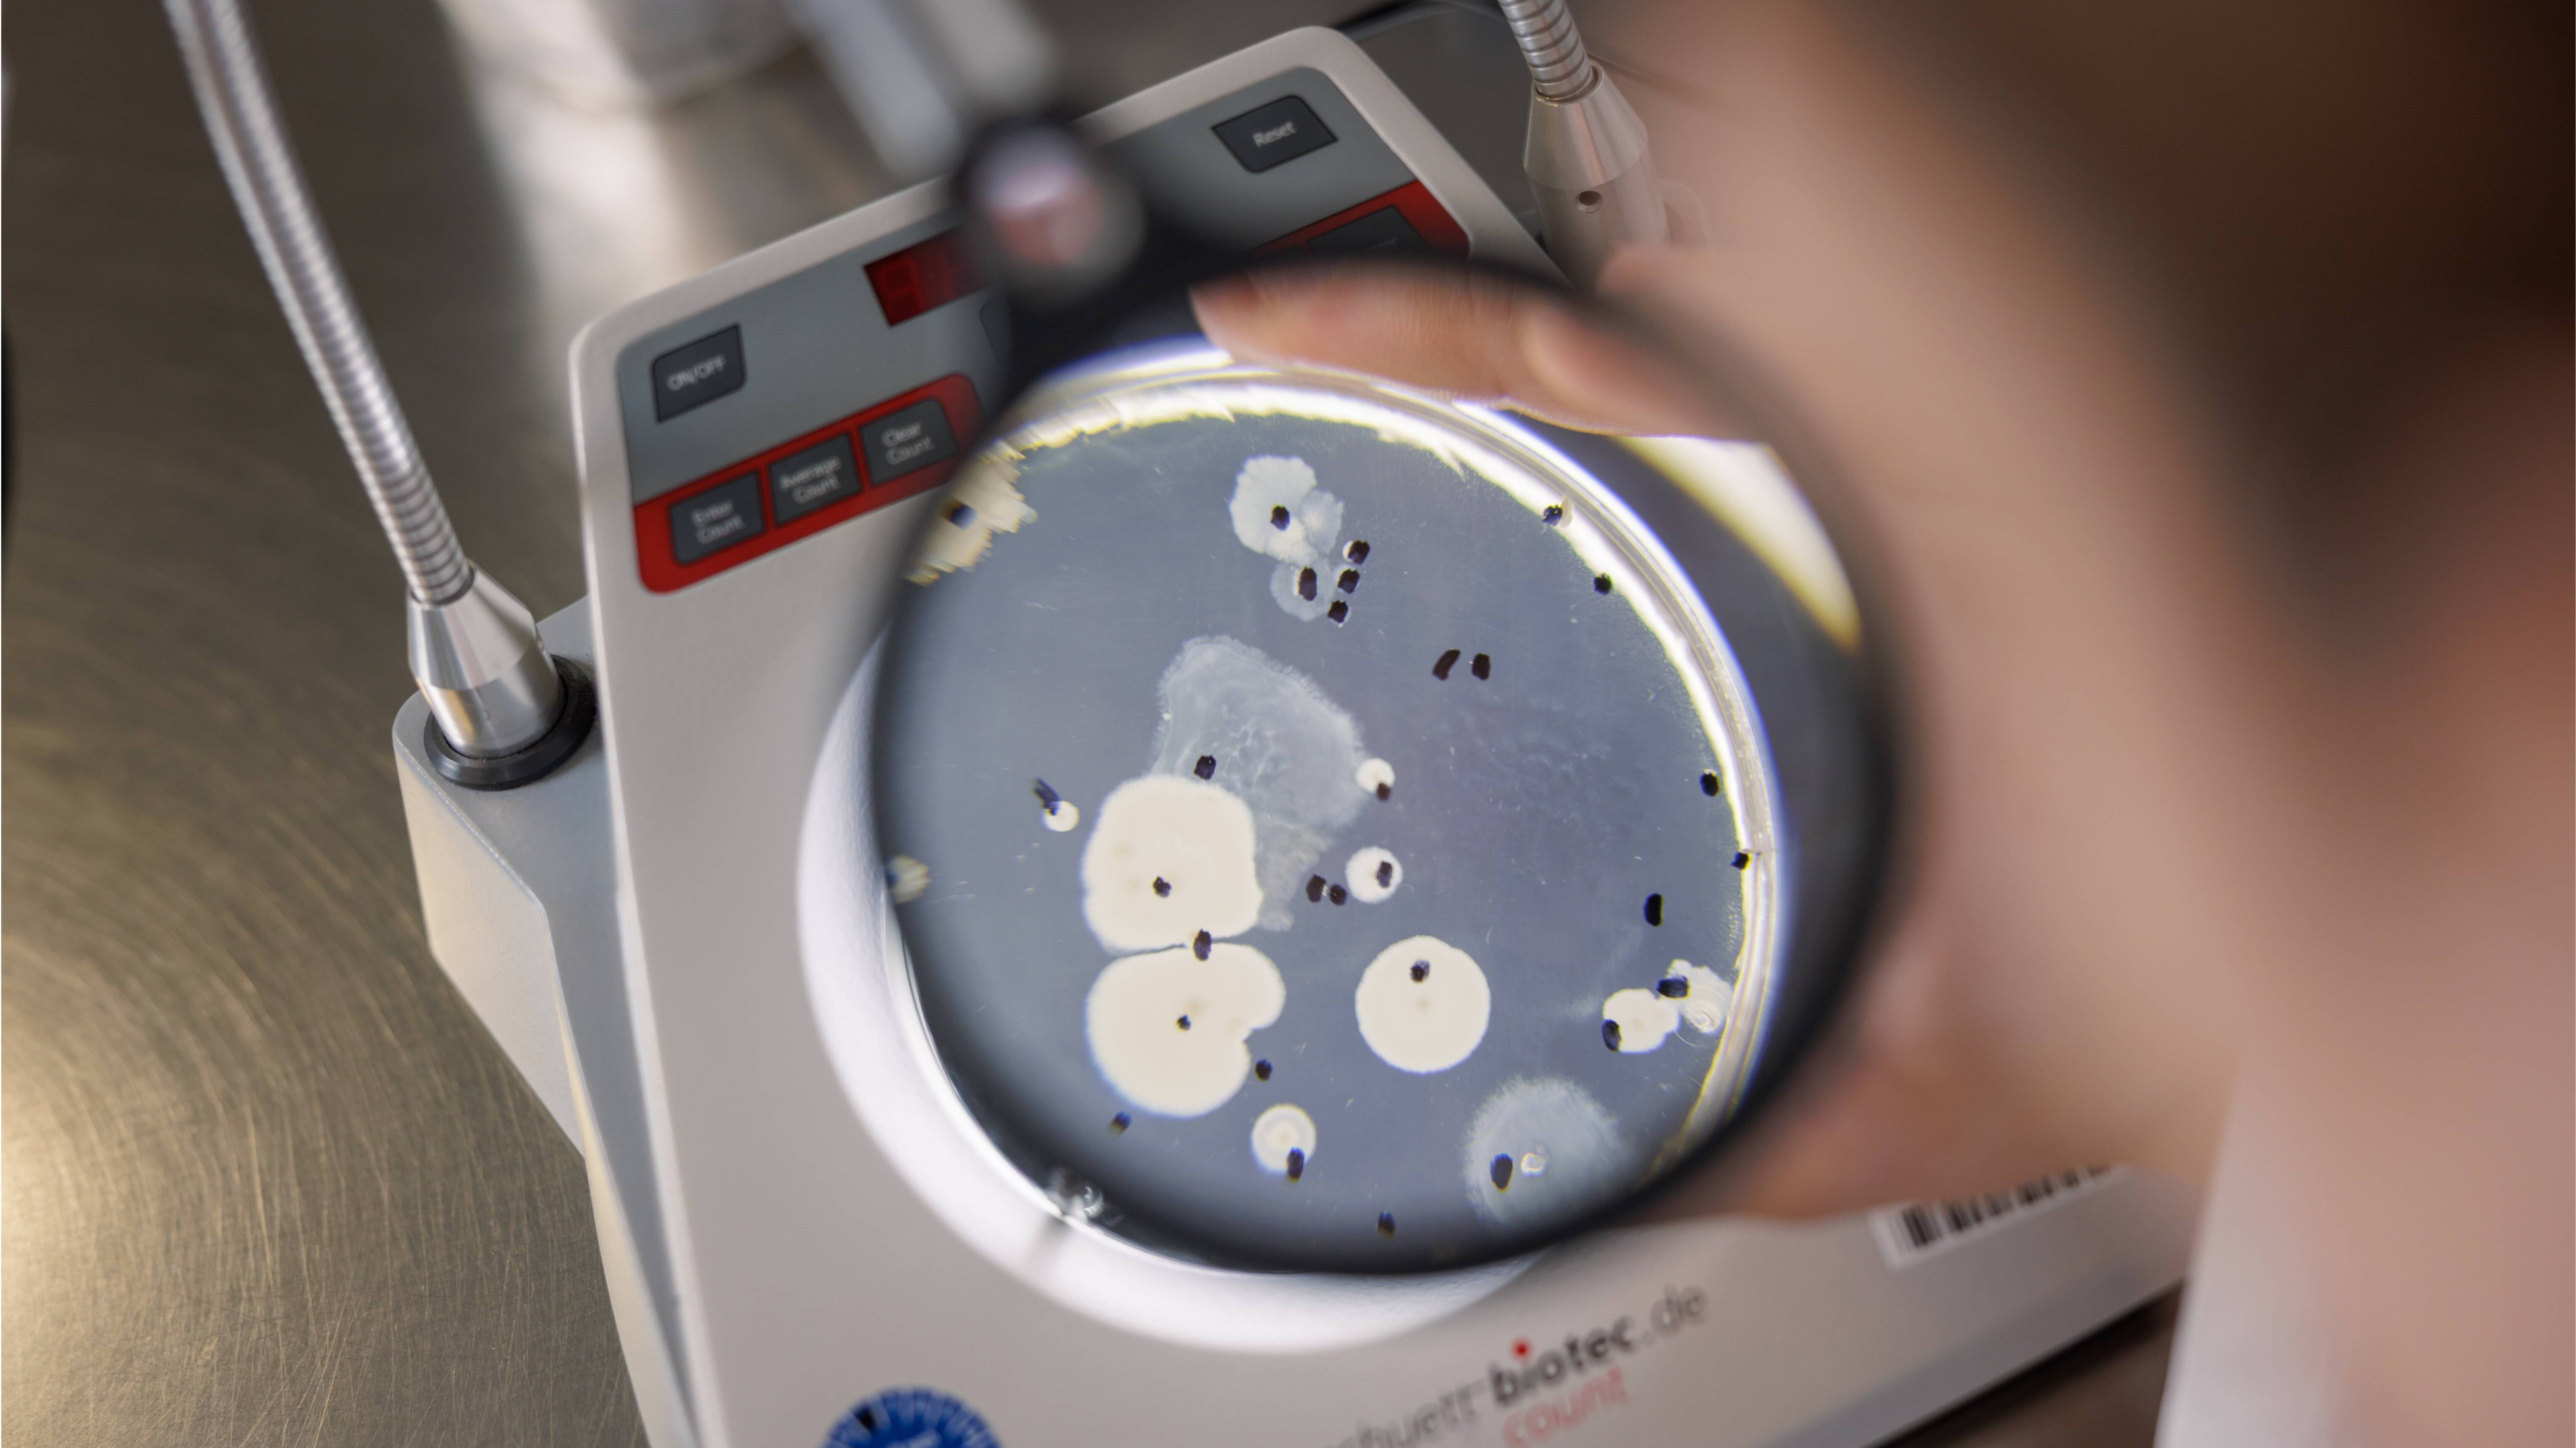

Sauberes Wasser für Niedersachsen - Arbeiten im Wasserlabor
Sauberes Trinkwasser ist für uns selbstverständlich – doch dahinter steckt präzise Arbeit, hohe Verantwortung und ein starkes Team. Im Wasserlabor des Niedersächsischen Landesgesundheitsamts (NLGA) sorgen Fachkräfte täglich dafür, dass die Qualität unseres Trinkwassers stimmt. Einer von ihnen ist Christian Wiesener, Probenahme-Manager im Bereich Trinkwasserhygiene.
Zwischen Labor, Lehre und Verantwortung
Christian Wiesener schult das Probenahmepersonal, das Trinkwasserproben aus ganz Niedersachsen ins Wasserlabor bringt. Dazu gehört nicht nur die Vermittlung der richtigen Probenahmetechniken, sondern auch die regelmäßige Kontrolle der Messgeräte sowie die Überarbeitung von Dokumenten nach aktuellen wissenschaftlichen Standards. Besonders reizvoll findet er die Kombination aus Fachwissen und Didaktik: „In meinem Biologiestudium habe ich mich schon früh für Didaktik interessiert. In meinem Job kann ich beides ideal verbinden.“
Ein abwechslungsreicher Arbeitsalltag
Das Wasserlabor ist ein Routinelabor mit klaren Abläufen – und dennoch kein Tag wie der andere. Morgens werten die Laborantinnen und Laboranten mikrobiologische Proben aus, bei denen unter anderem krankheitserregende Keime identifiziert werden. Parallel werden chemische Parameter untersucht, die ebenfalls gesundheitsschädlich sein können. Mittags trifft das von Christian geschulte Probenahmepersonal ein, um die Proben abzugeben. Hier zeigt sich, wie wichtig sauberes Arbeiten bereits vor der eigentlichen Analyse ist – denn Fehler bei der Probenahme lassen sich im Labor nicht mehr korrigieren.
Hightech für unsere Gesundheit
Zum Einsatz kommen moderne Analyseverfahren wie Massenspektrometrie, Chromatografien oder mikrobiologische Filterverfahren. Bei speziellen Fragestellungen nutzt das NLGA auch innovative Methoden wie Next Generation Sequencing (NGS) oder MALDI-TOF, um Keime exakt zu identifizieren und Infektionswege nachvollziehen zu können.
Warum Präzision Leben schützt
Im Wasserlabor zählen Genauigkeit und Sorgfalt – teilweise im Nanogramm-Bereich. Schon kleinste Unachtsamkeiten können Ergebnisse verfälschen. Deshalb legt Christian großen Wert auf regelmäßige Schulungen und praktische Übungen für das Probenahmepersonal. Seine Arbeit bildet die Basis dafür, dass Entscheidungen zum Trinkwasser-, Umwelt- und Gesundheitsschutz fundiert getroffen werden können.
Lernen, weiterdenken, vernetzen
Aktuell entwickelt Christian E-Learning-Module für das Probenahmepersonal. Sie ermöglichen flexibles Lernen, sichern Wissen durch Tests und helfen, kritische Arbeitsschritte immer wieder zu vertiefen. Gleichzeitig schätzt er die enge Vernetzung mit Gesundheitsämtern und anderen Fachbereichen im NLGA – der Blick über Abteilungsgrenzen hinweg ist ausdrücklich erwünscht.
Ein Arbeitgeber mit Perspektive
Seinen Weg beim NLGA beschreibt Christian als echte Entwicklungsgeschichte: von der Ausbildung zum Laboranten über den Außendienst bis hin zum Studium der Biologie – alles begleitet und gefördert durch seinen Arbeitgeber. Flexible Arbeitszeiten, Vertrauen und Entwicklungsmöglichkeiten machen das NLGA für ihn besonders attraktiv.
„Am Ende des Tages weiß ich, wofür ich es mache“
Was ihn täglich motiviert? Das Team, klare Routinen und gleichzeitig neue Herausforderungen. Vor allem aber das Wissen, einen sinnvollen Beitrag für die Gesundheit der Menschen in Niedersachsen zu leisten.
Sein Rat an Interessierte: „Der öffentliche Gesundheitsdienst ist längst nicht mehr altbacken. Wer sich einbringt und nach Möglichkeiten fragt, kann hier viel bewegen – fachlich wie persönlich.“